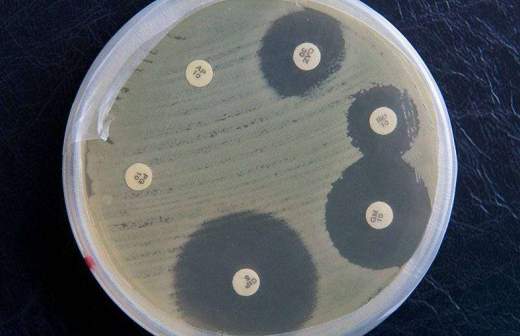

Израильские исследователи нашли средство от рака поджелудочной железы

В Израиле провели эксперименты с молекулой, способной уничтожить клетки рака поджелудочной железы. Об этом «РИА Новости» в пятницу, 20 декабря, рассказала профессор медицинского факультета Тель-Авивского университета Малка Коэн-Армон.
В ходе исследований специалисты подсадили больные клетки лабораторным мышам, после чего внедрили в животных молекулу PJ34. Некоторым мышам на протяжении 14 дней ставили капельницу, после чего на месяц терапию прекратили и проверили результат. Выяснилось, что раковые клетки исчезли на 90%.
Коэн-Армон объяснила, что полностью опухоль не исчезает только потому, что при раке поджелудочной железы она наполовину состоит из здоровых клеток, которые помогают раковым развиваться.
Ученые утверждают, что молекула PJ34 вынуждает раковые клетки запускать механизм самоуничтожения, при этом здоровые клетки она не затрагивает.
По словам профессора, на данный момент препарат вводят через капельницу, но в законченном виде лекарство, скорее всего, будет выпускаться в таблетках.
Ранее в этот же день сообщалось, что российские ученые создали лекарство от рака груди в виде инъекции.